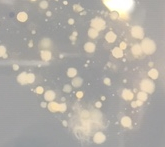

Symbiosis
Sponge microbe symbiosis
Sponges have been around in the fossil record for ~600 million years, and as far as we can tell, they have had a symbiotic association with microbes for just as long. The microbes that live in sponges are taxonomically diverse and can be highly abundant, comprising up to 40% of the sponge body by volume! These microbial ‘symbionts’ are generally considered to be commensal, meaning they don’t harm or benefit the sponge host. It is possible that we just don’t know what benefits the microbes are providing to the sponge or the other way around, and that is an area of ongoing research in my lab.
Questions on this topic that are addressed in my lab include: Do certain microbes provide necessary nutrients such as vitamins or amino acids to the sponge? Does this allow the sponge to take advantage of certain habitats (related to depth, sunlight, temperature, nutrient levels, pH)? Are these microbes necessary for sponge survival, and if so, how does the association start and continue (is there recognition of certain microbes by the sponge or do microbes ‘hide’ from the sponge)? Currently, a graduate student in my lab is examining how microbial symbionts may influence sponge development and life cycle. She is using freshwater sponges, which form resting bodies called gemmules which can survive harsh conditions and hatch into a new sponge when conditions are favorable again (e.g., after winter or after desiccation).

Most of my work on symbiosis has been focused on Caribbean sponge species and I will continue such work as my colleagues and I have a NSF-funded project in Panama starting in summer 2019. I also have local projects where my students and I are identifying which sponge species are found in rivers in Western North Carolina and characterizing their microbial communities. The photos below are from our first full field season in the summer of 2017 and a few more recent ones as we explore the region. We have observed at least four species so far in the rivers and I expect there are more out there. We are currently working to confirm the taxonomy of the sponges and characterize the taxonomy and functional profiles of the microbes that live within these sponges.
Symbiosis in other systems

I and two colleagues at ASU, Dr. Suzanna Brauer and Dr. Nathan Mowa are piloting a microbiome project aimed at understanding connections between diet, the gut microbiome, and pre-term birth using a mouse model. We are digging into data analysis on our pilot study now and excited to see where this leads.
Banner image: A section of sponge tissue viewed with fluorescence microscopy. The green background is the sponge tissue and the small orange dots are a type of photoautotrophic bacteria called cyanobacteria. The black holes are canals in the sponge tissue. Photo by Dr. Cole Easson, Nova Southeastern University.





